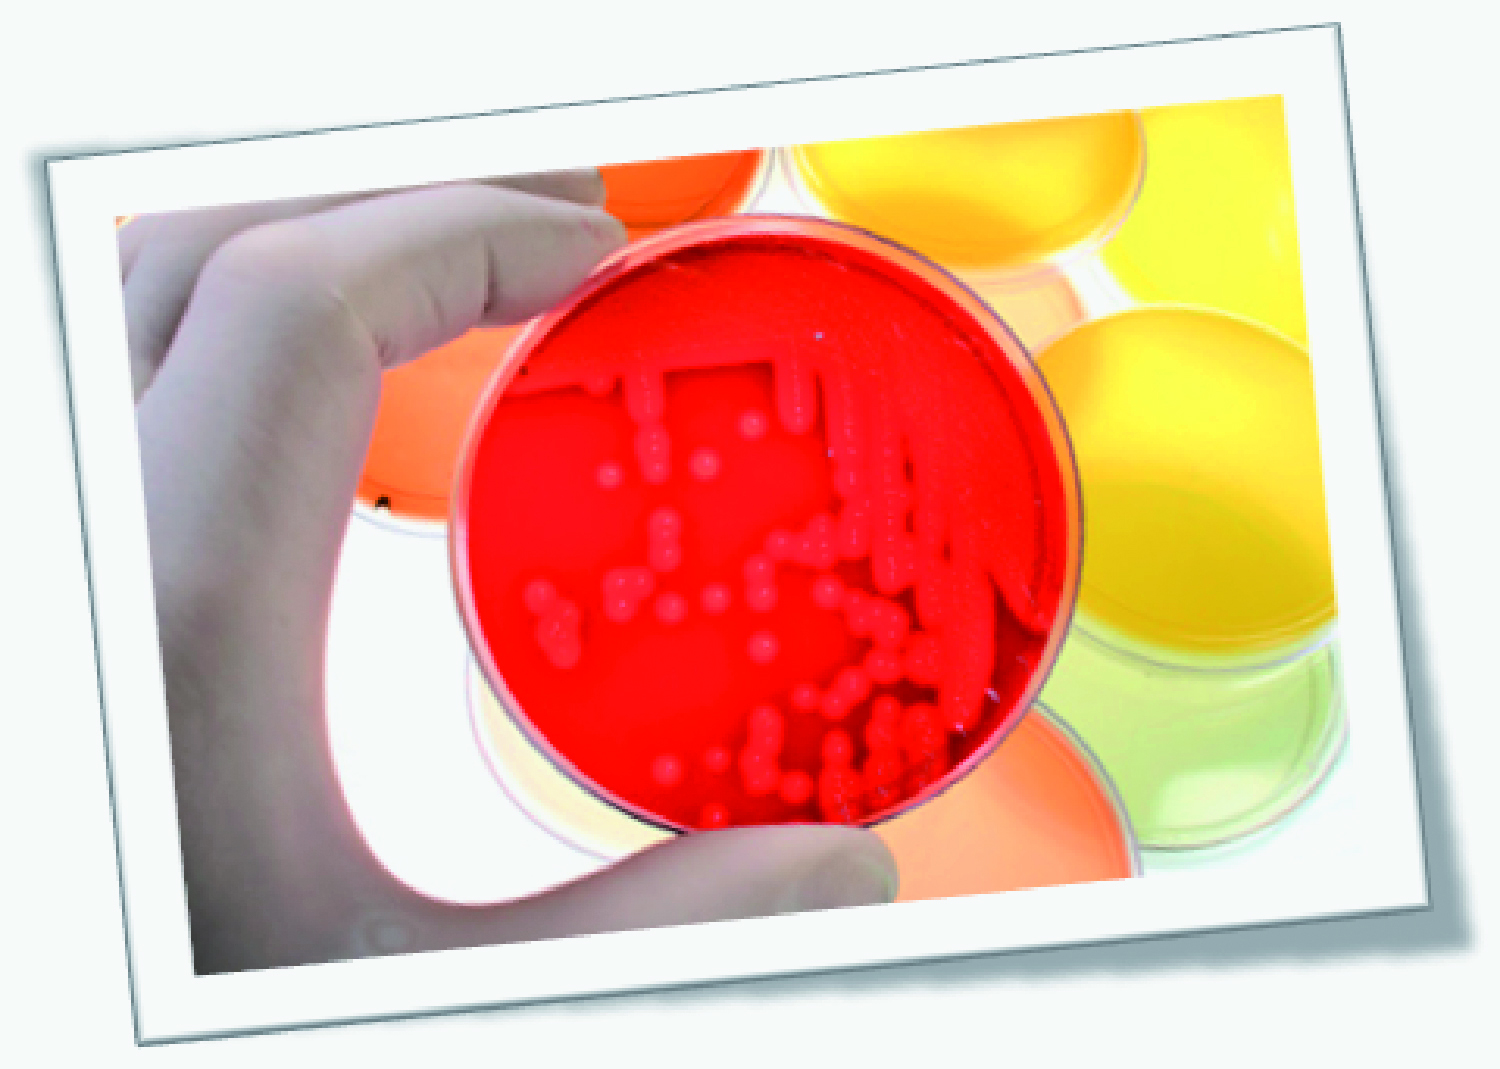

Proseguiamo e terminiamo con la seconda parte l’argomento iniziato nel numero scorso Fra gli obblighi di legge riconducibili al sistema di autontrollo vi è inoltre la gestione della documentazione. Tutte le schede di sicurezza dei prodotti chimici utilizzate nell’attività vanno conservate in apposito fascicolo. Alla stessa stregua, andranno conservate le schede relative alla Formazione Obbligatoria […]